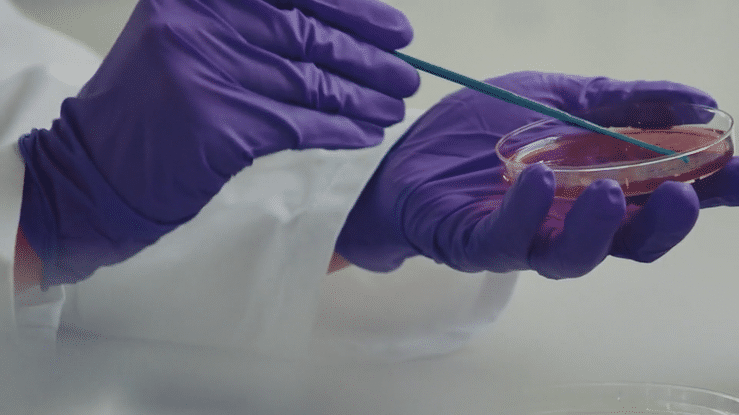

BIOTECH & HEALTH
Founder Patrick Mason graduated with a degree in biology and has been using his unique expertise to power Biotech and Healthcare projects ever since. He knows his way around a laboratory just as well as a film set and will even tell you how to un-fog your safety goggles so you can look at the monitor. This unique pairing has led him to work with premiere scientific and health care brands like Thermo Fisher, Labcorp, Jardiance, Lartruvo, and Eli Lilly, even winning a Clio Grand and Cannes Silver Lion.